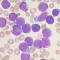
thumbnail preview

Vijesti označene tagom: leukemija

U zdravom tijelu zdrav duh stara je maksima koje se, naravno, treba držati, no ona jednako tako funkcionira i u obrnutom smjeru - da biste bili fizički zdravi, trebat biti zdravi u glavi. Tako su statističi podaci koje su znanstvenici s tri sveučilišta obradili utvrdili povezanost između…

U svakom slučaju, bilo koji posao da radite, suočeni ste s određenim zdravstvenim rizikom, a lista poslova u nastavku se povezuje sa rizikom od limfoma, leukemije i drugih vrsta raka. Ukoliko i vi radite jedan od ovih poslova, ne mora značiti da ćete odmah oboljeti. Tako prema izvještaju…

Kolegica Vesna Ravenščak oboljela je od leukemije. Kako bi joj pokazali da smo uz nju, a i pomogli da prebrodi ovu tešku bolest, želimo okupiti sve koji joj žele i na ovaj način pomoći. Cjelokupni prihod ove predstave namijenjen je našoj kolegici i prijateljici. Informacije…

"Ovo je uistinu uzbudljivo otkriće", izjavila je Dr. Janis Abkowitz sa Sveučilišta Washington iz Seattlea i predsjednica američkog udruženja hematologija. "Sad možemo uzeti stanice pacijenta i programirati ih da napadnu rak. Naime, znanstvenici…

Josip Kuže, igrač i trener Dinama i brojnih klubova umro je danas od leukemije. Kužeu su u veljači ove godine dijagnosticirali zloćudnu bolest, a kako je već uznapredovala, bitku je, nažalot, izgubio za samo 4 mjeseca. Josip Kuže rodio se 13.…

Znanstvenici iz Memorijalnog centra za izučavanje raka Sloan-Kettering u New Yorku objavili su rezultate eksperimentanlnog liječenja usmjerenom imunoterapijom koji daje nadu oboljelima od raka bijelih krvnih zrnaca. Svi tretirani pacijenti su doživjeli…

Nakon uspješne transplantacije koštane srži, dvojci mušakraca su se uspjeli riješiti HIV virusa. Od te operacije je prošlo više od dvije godine, a virusu ni traga. Liječnici ipak kažu kako je prerano reći…

Nakon što mu je ranije ovog tjedna dijagnosticiran akutni oblik leukemije, slavni kapetan bugarske nogometne vrste i Aston Ville Stilijan Petrov objavio je naprasni kraj karijere, prenosi Hina. "Ovo je kraj, za mene je nogomet završio.…

Istraživanje francuskih stručnjaka za nuklearnu sigurnost pokazalo je kako je broj djece oboljele od leukemije više nego dvostruko veći u blizini nuklearnih elektrana nego je to slučaj s drugim dijelovima zemlje, prenosi Hina. Francuska koristi…

Iako znanstvenici već duže vrijeme nagađaju kako bi aktivni sastojci popularne ulične droge ecstasy mogli imati i neke blagotvorne učinke na zdravlje, sve do sada nije provedeno niti jedno veliko istraživanje koje bi nedvojbeno dokazalo tako nešto.…

Medicinski znanstvenici to nazivaju prijelomnim uspjehom: leukemija je uspješno liječena ubrizgavanjem u krvotok oboljelih osoba genski izmijenjenih imunih stanica koje su usmrtile rak. Znanstvenici Centra za rak Abramson, pri Sveučilištu…

"Zapravo mi je teško sročiti što Vas točno želim zamoliti, znam, rekla sam na početku 10 minuta, ali nisam bila sasvim iskrena. Nemojte zamjeriti, nije mi lako. Sve moje želje zapravo stanu u dvije riječi - ŽELIM ŽIVOT...", napisala…

Zahvaljujući brzom napretku regenerativne medicine, šećerna bolest tip I, Parkinsonova bolest, ozljede leđne moždine ili infarkt srca u skoroj će budućnosti predstavljati manju prijetnju po zdravlje i život čovjeka. U prvom planu ove grane…
Znanstvenici su pronašli način za razoružavanje proteina za kojeg se pretpostavlja daima ključnu ulogu u nastanku leukemije i ostalih vrsta raka. Otkriće će sigurno povećati nadanja u terapiju koja bi se uspješno mogla suprotstaviti…

Kareem Abdul-Jabbar, jedna od najsjajnijih zvijezda NBA lige i svjetske košarke uopće, izjavio je u utorak da ima rak. Sportska je legenda javno obznanila vijest o svojoj bolesti skoro godinu dana nakon što joj je dijagnosticirana kronična…